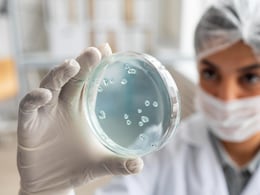
India Develops New Antibody Discovery Platform To Transform Diagnostics

Antibody Test
-
{
- All
- News
- Videos
-

India Develops New Antibody Discovery Platform To Transform Diagnostics
- Wednesday January 21, 2026
- Health | Indo-Asian News Service
A team of researchers at the Indian Institute of Technology (IIT) Roorkee on Tuesday announced the development of a next-generation antibody discovery platform that has the potential to transform diagnostics and therapeutics.
-
 www.ndtv.com
www.ndtv.com
-

UK Rolls Out New Antibody Test Programme For COVID-19 Positives
- Sunday August 22, 2021
- World News | Press Trust of India
The UK government on Sunday announced the rollout of a new nationwide antibody surveillance programme, which will make free home antibody tests available for up to 8,000 COVID-positive people a day.
-
 www.ndtv.com
www.ndtv.com
-

Antibody Tests Get A Questionable Second Life
- Friday June 11, 2021
- World News | Kristen V Brown and Emma Court, Bloomberg
Commerical antibody tests were developed to measure recent infection from the virus, rather than the vaccine response. They cant reliably establish whether a person is immune to COVID-19.
-
 www.ndtv.com
www.ndtv.com
-

Top Medical Body Issues Guidance On Rapid Antibody Test Kits For COVID-19
- Thursday May 14, 2020
- India News | Press Trust of India
The ICMR on Wednesday issued guidance on rapid antibody test kits for COVID-19 and listed their manufacturers, which include two Chinese firms whose importer licenses were cancelled by the CDSCO after kits supplied by them showed wide-variation under field conditions.
-
 www.ndtv.com
www.ndtv.com
-

India Overpaid For Chinese COVID-19 Test Kits? What Court Case Reveals
- Monday April 27, 2020
- India News | Reported by Arvind Gunasekar, Edited by Deepshikha Ghosh
India paid double for Chinese Rapid Antibody Tests for coronavirus, which have been put on hold in many states because of faulty results.
-
 www.ndtv.com
www.ndtv.com
-

Bengal To Use Pool Testing, Rapid Antibody Method For COVID-19
- Monday April 20, 2020
- India News | Reported by Monideepa Banerjie, Edited by Debanish Achom
The West Bengal government will start rapid antibody and pool testing to detect COVID-19 patients, the state government said in a statement. Mass testing for coronavirus can be made low cost by pool testing - conducting tests of groups of five persons as a poll, the Indian Council of Medical Research (ICMR) has said.
-
 www.ndtv.com
www.ndtv.com
-

India Develops New Antibody Discovery Platform To Transform Diagnostics
- Wednesday January 21, 2026
- Health | Indo-Asian News Service
A team of researchers at the Indian Institute of Technology (IIT) Roorkee on Tuesday announced the development of a next-generation antibody discovery platform that has the potential to transform diagnostics and therapeutics.
-
 www.ndtv.com
www.ndtv.com
-

UK Rolls Out New Antibody Test Programme For COVID-19 Positives
- Sunday August 22, 2021
- World News | Press Trust of India
The UK government on Sunday announced the rollout of a new nationwide antibody surveillance programme, which will make free home antibody tests available for up to 8,000 COVID-positive people a day.
-
 www.ndtv.com
www.ndtv.com
-

Antibody Tests Get A Questionable Second Life
- Friday June 11, 2021
- World News | Kristen V Brown and Emma Court, Bloomberg
Commerical antibody tests were developed to measure recent infection from the virus, rather than the vaccine response. They cant reliably establish whether a person is immune to COVID-19.
-
 www.ndtv.com
www.ndtv.com
-

Top Medical Body Issues Guidance On Rapid Antibody Test Kits For COVID-19
- Thursday May 14, 2020
- India News | Press Trust of India
The ICMR on Wednesday issued guidance on rapid antibody test kits for COVID-19 and listed their manufacturers, which include two Chinese firms whose importer licenses were cancelled by the CDSCO after kits supplied by them showed wide-variation under field conditions.
-
 www.ndtv.com
www.ndtv.com
-

India Overpaid For Chinese COVID-19 Test Kits? What Court Case Reveals
- Monday April 27, 2020
- India News | Reported by Arvind Gunasekar, Edited by Deepshikha Ghosh
India paid double for Chinese Rapid Antibody Tests for coronavirus, which have been put on hold in many states because of faulty results.
-
 www.ndtv.com
www.ndtv.com
-

Bengal To Use Pool Testing, Rapid Antibody Method For COVID-19
- Monday April 20, 2020
- India News | Reported by Monideepa Banerjie, Edited by Debanish Achom
The West Bengal government will start rapid antibody and pool testing to detect COVID-19 patients, the state government said in a statement. Mass testing for coronavirus can be made low cost by pool testing - conducting tests of groups of five persons as a poll, the Indian Council of Medical Research (ICMR) has said.
-
 www.ndtv.com
www.ndtv.com